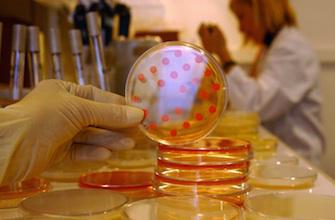

« Si vous voulez enterrer un problème, créez une commission », disait Georges Clémenceau. Ces instances de réflexion sont effectivement légions en France. Au nom de la modernisation de l’action publique, le gouvernement de Jean-Marc Ayrault a donc décidé de faire le ménage. 101 commissions sont supprimées dont 12 dans le domaine de la santé. Terminés entre autres le comité de lutte contre la grippe, le comité de suivi du plan de lutte contre la douleur et celui du plan pour préserver l’efficacité des antibiotiques. Pour les spécialistes des maladies infectieuses, voir le plan Antibiotiques passer ainsi en pilote automatique est un sérieux sujet de préoccupation.
Ecoutez le Dr Rémi Gauzit, infectiologue, anesthésiste réanimateur à l’Hotel Dieu à Paris, et membre de ce comité défunt : « Je suis atterré, c’est une décision aberrante pour la santé publique. »
C’est en effet un plan crucial pour la santé publique qui perd son chef d’orchestre. « Les bactéries résistantes aux antibiotiques sont responsables de 25 000 morts par an en Europe. Ce n’est pas une menace anecdotique », s’étrangle Jean-Paul Stahl, infectiologue au CHU de Grenoble. La situation est même de plus en plus préoccupante. En 2010, l’inquiétude portait sur l’Inde et sa bactérie NDM-1 résistante à tous les antibiotiques courants. Trois ans plus tard, la désorganisation des hôpitaux du Maghreb depuis le printemps arabe et celle des hôpitaux grecs, italiens ou espagnols en proie à la crise économique et aux coupes budgétaires a rapproché la menace. Y compris pour les maladies infectieuses les plus banales. Aujourd’hui en France, on chiffre à 70 000 par an le nombre d’infections urinaires que les médecins généralistes ne peuvent plus soigner avec des antibiotiques classiques.
Avec les plans nationaux successifs et l’implication de l’Assurance Maladie, la France s’était clairement attaquée au problème. Même si le plan pour préserver l’efficacité des antibiotiques continue de courir jusqu’en 2016, la suppression de son comité de suivi fait figure d’enterrement pour les spécialistes des maladies infectieuses.
Officiellement, le pilotage du plan sera désormais assuré au niveau local par chacune des agences régionales de santé (ARS). Certaines régions ont d’ailleurs déjà pris des initiatives. C’est le cas de l’Ile-de-France qui vient d’ouvrir une permanence téléphonique pour aider les médecins de ville en demande de conseils précis lorsqu’ils doivent faire face à une antibiorésistance. Cette initiative a été conçue par les sociétés scientifiques de médecine générale et avec la société de pathologie infectieuses de langue française (SPILF). Mais pour ces mêmes experts, ce type d’actions locales ne saurait suffire.
Ecoutez le Pr Jean-Paul Stahl, infectiologue au CHU de Grenoble : « Les bactéries ne connaissent pas les ARS et elles circulent avec le TGV ! On a absolument besoin d’un plan national voire européen »
L’incompréhension des infectiologues face à cette décision est totale. Même l’argument des temps de rigueur peut être écarté puisque le plan, en luttant contre la prescription d’antibiotiques à mauvais escient, était source d’économies pour la sécurité sociale.